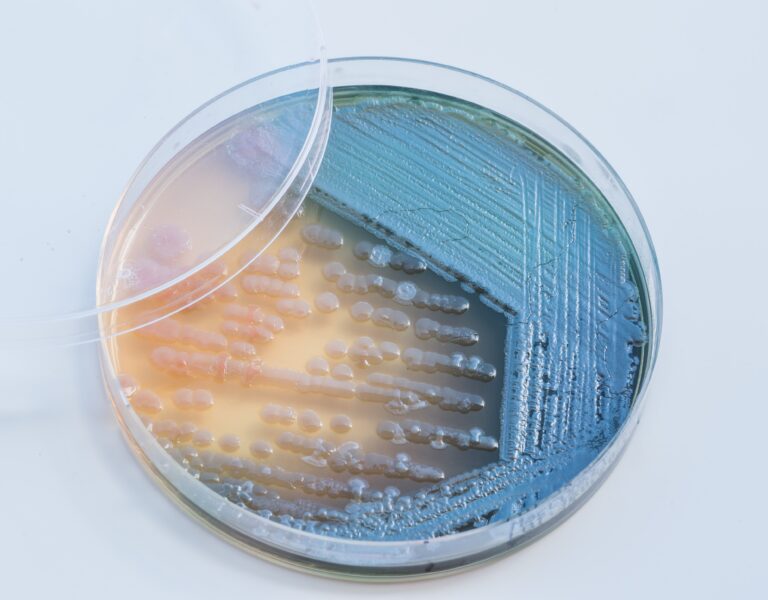
Bacterial colonies culture on  selective agar media XLT Agar (Xy

Our Products
PerHydrogen manufactures ready-to-use culture media in plate, tube, and bottle formats. Our facility and robotic filling systems—designed entirely in-house—enable the production of over 150 products that meet international standards. These serve clinical, pharmaceutical, personal care, food safety, water testing, and environmental applications.
Product Catalogue
Culture Media
-
Conventional Agar
A comprehensive selection of standard agar media formulated to support the recovery and cultivation of pathogenic microorganisms from clinical specimens.
-
Bi-plates
Each KHANYI bi-plate combines chromogenic agar with either a conventional medium or a second chromogenic medium, delivering efficiency and versatility.
-
Chromogenic
The innovative KHANYI range of chromogenic media (trial) is the easy way to rapidly and reliably detect and identify microorganisms.
-
Tube Media
Offering a wide variety of ready-to-use Prepared Tube Media, ideal for cultures requiring prolonged incubation.
-
Bottled Media
perHydrogen's ready-for-use prepared bottled media will help detect microorganisms from pharmaceutical, food, environmental or water testing samples.
-
Viral Transport Medium
Our viral transport medium is designed to preserve clinical viral specimens (e.g. Ebola, Mpox, MVD, SARS‑CoV‑2) after collection, enabling secure transport and subsequent laboratory analysis.